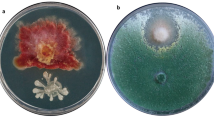

Abstract
Food security is a global concern, and it is a substantial challenge to feed the ever-increasing population. The anthropological operations, abiotic and biotic stresses, have limited the crop productivity to a great extent. Phytopathogens are the major biotic constraints and pose a significant threat to food production. The extensive utility of hazardous chemicals for pathogen control is unhealthy to mankind and environment as well. In this context alternative strategies or agents that are operative in terms of cost-effectiveness, feasibility, and practicality for sustainable agricultural production are imperative. Biocontrol agents comprising of bacteria, fungi, raw plant materials, and vermicompost have become attractive in terms of pathogen control and improved crop productivity. This chapter describes the immense role of biocontrol agents in pathogen suppression and sustainable crop production. Various strategies such as production of bioactive compounds and mechanisms adopted by biocontrol agents to fight pathogens with convincing examples are discussed. Furthermore, emerging biocontrol strategies covering both conventional and biotechnological approaches that are in infancy and their emphasis as a need for improved crop production are also discussed. The major challenge is to develop cost-effective spray bio-formulations and new application methods feasible for practical applications against a broad range of phytopathogens. Undoubtedly, exploitation of biocontrol agents/strategies offers a promising ray to address food security, in particular when well optimized for a particular plant and/or soil type.
Access provided by Autonomous University of Puebla. Download chapter PDF
Similar content being viewed by others
Keywords
4.1 Introduction
The substantial pressure on land for agricultural farming due to increased urbanization, rapid changes in the agroclimatic conditions, and rising population led to the emergence of alarming food security globally. In addition, yield losses in agricultural crops caused by plant pathogens/pests such as viruses, bacteria, fungi, oomycetes, nematodes, insects, and mollusks pose a significant risk. Estimates reveal that the crop loss due to plant pathogens in Western countries is approximately 25% while that in developing countries is as high as 50% (Dubey et al. 2015; reviewed by Aboutorabi 2018). Annually it is estimated that plant diseases, either directly or indirectly, account for losses worth 40 billion dollar worldwide (Roberts et al. 2006). These plant pathogens are major biotic constraints of food production and have led to severe disasters in the past significantly impacting human history, for instance, the Irish potato famine resultant of Phytophthora infestans (1840s), the Great Bengal rice famine resultant of Cochliobolus miyabeanus (1943), the Bengal brown leaf spot disease of rice due to Helminthosporium oryzae (1940s), and the USA epidemic of southern corn leaf blight, caused by Bipolaris maydis (1970–1971), among others. While effective management stratagems such as the development of resistant varieties and genetically engineered cultivars and usage of agrochemicals were employed to tackle these diseases, they do have loopholes. Developing a disease-resistant variety through conventional breeding is time-consuming, and the resistant trait is effective against only a few diseases. Likewise, crop plants engineered for resistance via genetic engineering face environmental risks and public concerns and have not been approved by national governmental policies. So far, the effective means of disease control had been achieved by the use of agrochemicals. However, they are cost-intensive, hazardous, and environmentally unfriendly as they severely affect soil fertility, microfauna, and human health (Aktar et al. 2009; Prashar and Shah 2016). The extensive usage of chemical pesticides results in their accumulation in plant tissues, inhibition of beneficial microbes, environmental contamination, and the emergence of disease-resistant pathovars. The reckless usage of chemicals is detrimental to organisms across all taxonomical hierarchies (Kawahara et al. 2005; Rastogi et al. 2010; Mnif et al. 2011; Schwartz et al. 2015). Some of the biotic catastrophes encompass algal bloom (Heisler et al. 2008), coral bleaching (Danovaro et al. 2008), mass death of bees (Kasiotis et al. 2014), food chain contamination (Chen et al. 2007), avian reproductive loss (Jagannath et al. 2008), and mad cow disease (O’Brien 2000). In India, the rising trend of farmer suicide is partly linked to the depressive effects of the pesticides (Chitra et al. 2006). Organophosphates have been consistently linked to cancers and neurological disorders (Rastogi et al. 2010; Neupane et al. 2014). In this regard, much attention has to be paid toward alternative disease management strategies that are free from environmental risks and other related issues. The recruitment of biological control agents (BCA) as control measures against phytopathogens seems to be a quite promising approach.
Among the various phytopathogens, root pathogens significantly affect the root system and interfere with nutrient utilization and water uptake of plants, thus causing severe yield losses. Generally, root systems secrete specific exudates to the soil which improve plant nutrient availability and encourage the interaction with the rhizospheric beneficial microbes (Broeckling et al. 2008; Carvalhais et al. 2011; Trivedi et al. 2017). The rhizospheric area is the nutrient-wealthy zone of the soil due to a variety of chemicals such as auxins, peptides, amino acids, and sugars, liberated by the roots (Carvalhais et al. 2011; Takahashi 2013). Several crops are vulnerable to root diseases caused by bacteria and fungi (Alstrom and Van Vurde 2001; Maheshwari 2012). A diverse range of microorganisms thrive in the rhizosphere. Bacteria compete for the rhizospheric niche due to its resistance to climatic and edaphic fluctuations, unlike phylloplane region (O’Callaghan et al. 2006). The bacteria residing in this habitat are known as rhizobacteria (Prashar et al. 2014; Alsohim et al. 2014; Ali et al. 2014).
Biological control is the technique which attempts to mitigate the plant disease by the use of a bacterium, virus, fungus, or a combination of them to the plant or the soil (D’aes et al. 2011; Maheshwari 2012; Guo et al. 2014). The biological control agents (BCA) inhibit the phytopathogen by various offense modalities (Pearson and Callaway 2003). The most important benefit of using BCAs is that they are specific for a pathogen and are likely to be inoffensive to nontarget species. Microbial antagonists which are used to suppress diseases in plants are termed as biocontrol agents (Maheshwari 2012). The plant diseases are generally suppressed by the antagonistic effect of bioagents which occupies the same rhizospheric zone and utilizes the same food as the pathogens (Berendsen et al. 2012; Prashar et al. 2014). In the last few decades, there have been many details of the wide range of applications of BCA for the plant root diseases management (Kloeppe et al. 1999; Kokalis-burelle 2002; Mavrodi et al. 2012). The data has been presented in Table 4.1. Eco-friendly and sustainable attributes of biocontrol have spurred intense research on the potential candidates.
For BCA to be marketable, apart from efficacy, two other key factors that must be fulfilled are safety and affordable cost. It is not easy to find such candidates, and biocontrol paradigms still lag behind in replacing the detrimental chemical-driven agro-market. Biological control can be achieved at several levels such as partial, substantial, and complete.
Crop plants have to deal with a gamut of pathogens, insects, and herbivores. Root diseases are major problems, which can sabotage the plant health. It is because the roots are vital for nutrition uptake and are in direct contact with an array of soil microorganisms. Soil-dwelling pathogens include Rhizoctonia, Verticillium, Phytophthora, Fusarium, Pythium, Sclerotinia, Rosellinia, etc. (Hussain and Khan 2020; Karima et al. 2012; Matny 2015; Mostert et al. 2017). How BCA might be used to control the root pathogens and to benefit farmers in developing countries is the focus of this article.
4.2 Merits and Demerits of Biological Control Agents (BCA)
BCA has two opposite facets like all remedies. While low-cost, mild, and eco-friendliness are its positive traits, its unpredictable efficacy is a major hurdle.
4.3 Mechanisms Adopted by Biological Control Agents
The BCA activity is mediated either directly by the antagonism of soilborne pathogens or indirectly by triggering plant defense responses (Pozo and Azcon-Aguilar 2007; Jamalizadeh et al. 2011). Direct antagonism results from physical contact with the pathogen or pathogen selectivity through the mechanisms expressed by the BCA. Elicitation of plant host defense system by BCA is considered as a direct form of antagonism. BCA employ several modalities to challenge the phytopathogens (Rahman et al. 2017). Such strategies include antibiosis through the production of antimicrobial compounds, competition for available nutrients and niches, disruption of pathogen signaling, and the elicitation of plant defenses (Sturz and Christie 2003; Bais et al. 2004; Compant et al. 2013). The schematic diagram below shows some of the pathogen-vanquishing modes of BCA (Fig. 4.1). The pathogen-disarming pathways have been described in the following sections.
4.3.1 Microbial Antagonisms
The microbes considered as ideal candidates for BCA have the ability to proliferate in the rhizospheres, a niche which defends the roots and acts hostile to pathogens. The advantageous microbes colonize the roots and secrete pathogen-antagonizing metabolites into the root system where they directly aid in the suppression of pathogenic bacterial growth (Shoda 2000). This microbial antagonism between beneficial microbes and pathogens is the most significant strategy of disease control, in which the metabolically active populations of beneficial microbes offer protection either by direct antagonism or by priming of host plant defenses (Nihorimbere et al. 2011). It also involves antibiosis, where the secretion of diffusible antibiotics, volatile organic compounds, toxins, and extracellular cell wall-degrading enzymes (such as chitinase, β-1,3-glucanase, beta-xylosidase, pectin methylesterase) is key to pathogen control (Shoda 2000; Compant et al. 2005).
4.3.2 Parasitism
Parasitism, the concept of one organism living off another, is ubiquitous. BCA exploit parasitism to control pathogens. They produce cell wall-lysing enzymes such as chitinases and glucosaminidases to degrade the cell wall of fungal pathogens, followed by penetration and killing (Guigon-Lopez et al. 2015). Trichoderma has been discovered to parasitize Macrophomina phaseolina and Pythium myriotylum, among others (Kubicek et al. 2001). A nematophagous fungus Pochonia chlamydosporia uses its proteases to infect the eggs of nematodes. The fungal infectivity of the nematode is enhanced by chitosan (Escudero et al. 2016).
4.3.3 Competition
When two or more than two organisms demand the same nutrition from one source for survival, the interaction becomes competitive. BCA exploit this nexus to deter pathogens. They prevent the establishment of pathogen by utilizing the same nutrients which are needed for the development and infectivity of the pathogen. A microbe must be able to tap the accessible nutrients in the form of exudates, leachates, or senesced tissue in order to thrive in the phyllosphere or rhizosphere. The niche surrounding the rhizosphere is a significant source of carbon (Roviara 1965), where the photosynthate allocation can be as high as 40% (Degenhardt et al. 2003). The nutrient abundance around root surfaces attracts a large diversity of microbes, both favorable and pathogens. Effective BCA compete for these nutrients and protects the plants from phytopathogens (Duffy 2001). This competition approach has been proven to be successful particularly for soilborne pathogens such as Fusarium and Pythium that infect through mycelial contact as compared to the pathogens that directly germinate on plant aerial surfaces. For instance, Enterobacter cloacae, a BCA, reduces the growth of Pythium ultimum by enhancing the catabolism of nutrients (van Dijk and Nelson 2000; Kageyama and Nelson 2003). Migration of BCA to the root surface is governed by the chemical attractants of the root exudates such as organic acids, amino acids, and specific sugars (Nelson 1990; Welbaum et al. 2004; De Weert et al. 2002). For example, Pseudomonas fluorescence consumed iron required for the pathogen Fusarium oxysporum, and Chryseobacterium sp. WR21 restrained Ralstonia solanacearum by claiming root exudates for itself (Huang et al. 2017).
4.3.4 Production of Antimicrobial Compounds
4.3.4.1 Antibiotics
The role of antibiotics as BCA has been recognized. Among others, polymyxin, circulin, and colistin are antibiotics generally produced by a number of Bacillus species, Antibiotics such as phenazines, phloroglucinols, pyoluteorin, pyrrolnitrin, cyclic lipopeptides, and hydrogen cyanide (HCN) affect pathogenic fungi as well as Gram-positive and Gram-negative bacteria. For antibiotics to act as effective BCA, they must be produced in proximity to the pathogens and in adequate amount (Weller et al. 2007; Mavrodi et al. 2012). Some of the antibiotics documented to suppress plant pathogen growth include 2, 4-diacetyl phloroglucinol (DAPG) (against Pythium spp.) (Weller et al. 2007), agrocin 84 (against Agrobacterium tumefaciens) (Kerr 1980), iturin A (against Botrytis cinerea and Rhizoctonia solani) (Kloepper et al. 2004), and phenazines (against Gaeumannomyces graminis var. tritici) (Thomashow et al. 1990). Several species of the genus Pseudomonas elaborate antifungal metabolites phenazines, pyrrolnitrin, DAPG, and pyoluteorin (Bloemberg and Lugtenberg 2001). Phenazine has redox activity, which can suppress phytopathogens such as F. oxysporum and Gaeumannomyces graminis (Chin-A-Woeng et al. 1998). Pyrrolnitrin produced by Pseudomonas chlororaphis DF190 and PA23 inhibits the fungus Leptosphaeria maculans, which causes blackleg lesion in canola (Ramarathnam et al. 2011). Trichoderma has emerged as an epitome of antagonism (Verma et al. 2007). The efficacy of Trichoderma virens-produced agrocin K84 in the management of Pythium damping off of cotton seedlings has been widely observed. Bacillus methylotrophicus R2-2 and Lysobacter antibioticus 13-6 inhibited tomato root-knot-causing nematode Meloidogyne incognita (Zhou et al. 2016). Lipopeptide class of surfactants secreted by Pseudomonas and Bacillus species have been intended as BCA for their antagonistic effect on bacteria, fungi, oomycetes, protozoa, and nematodes, among other pests. The role of antibiotics as effective BCA has been demonstrated by the inability of soilborne root disease suppression by the mutant strains of biocontrol bacteria that fail to produce phenazines and ploroglucinols (Keel et al. 1992; Thomashow et al. 1990).
4.3.4.2 Iron-Chelating Siderophores
Bacteria and fungi-derived siderophores can inhibit plant pathogens by competing for iron, copper, zinc, and manganese (Leong and Expert 1989; Bloemberg and Lugtenberg 2003). Siderophores are iron-chelating compounds, and they aid in the transport of iron across cell membranes (Neilands 1981; Hider and Kong 2010). The ability of BCA to compete for nutrients can limit the growth of pathogens (Handelsman and Parke 1989; Nelson 1990; Harman and Nelson 1994). Iron being an essential growth element for all life forms, its deficit in soil niche and on plant surfaces creates a furious competition (Leong and Expert 1989; Loper and Henkels 1997). Iron deficiency induces BCAs to produce siderophores to acquire ferric ion (Whipps 2001). Siderophore as a mechanism of biological control was first demonstrated by plant growth-promoting strains of Pseudomonas fluorescens such as A1, BK1, TL3B1, and B10 against the pathogen Erwinia carotovora (Kloepper et al. 1980). Siderophores with higher affinity for iron and sequestration ability have been widely observed in fluorescent pseudomonads (Loper and Buyer 1991; Sullivan and Gara 1992). Significance of P. fluorescens siderophores in plant pathology suppression has been demonstrated in the past (Costa and Loper 1994; Leong and Expert 1989). Owing to their potential role in disease suppression, engineered bacterial strains with enhanced production of siderophores could be developed.
4.3.4.3 Biocidal Volatiles
Volatile organic compounds (VOCs) are lipophilic substances with high diffusion tendency through biological membranes (Pichersky et al. 2006). The VOCs emitted by soil bacteria act above the ground as well as within the soil. Some VOCs act as signaling molecules and play critical role in communications (Kai et al. 2009). Microbial VOCs as a weapon of defense against pathogenic fungi have received substantial attention in recent times (Mackie and Wheatley 1999; Strobel et al. 2001; Fernando et al. 2005; Gu et al. 2007; Zou et al. 2007; Liu et al. 2008; Wan et al. 2008; Arrebola et al. 2010). VOCs from soil bacteria can impede the growth of phytopathogenic fungi (Alström 2001; Wheatley 2002). For example, the VOCs produced by rhizobacteria inhibit the growth of pathogenic fungus Sclerotiana sclerotiorum (Giorgio et al. 2015). Volatiles produced by the bacterial strains, Bacillus megaterium KU143 and Pseudomonas protegens AS15, significantly inhibited the growth of Aspergillus candidus, Aspergillus fumigatus, Penicillium fellutanum, and Penicillium islandicum in stored rice grains (Mannaa and Kim 2018). Volatile compounds from Trichoderma was able to restrain plant pathogens (Fusarium oxysporum, Rhizoctonia solani, Sclerotium rolfsii, Sclerotinia sclerotiorum, and Alternaria brassicicola) (Amin et al. 2010; Meena et al. 2017). However, correlation of VOCs with BCAs, plant pathogens, and plants, along with biotic and abiotic, factors is explored to a limited level (Campos et al. 2010).
4.3.4.4 Lytic Enzymes (Chitinases and Glucanases)
The prevention of potential plant pathogen is usually done by the battery of hydrolytic enzymes produced by the microbes extracellularly. For example, chitinase and β-1, 3-glucanase cleave chitin and β-1, 3-glucan, the major components of fungal cell walls (Lam and Gaffney 1993), resulting in its weakening followed by death (Chernin and Chet 2002). The production of chitinase by S. plymuthica, Serratia marcescens, Paenibacillus sp., and Streptomyces sp. was found to be inhibitory against Botrytis cinerea, Sclerotium rolfsii, and Fusarium oxysporum f. sp. cucumerinum (Ordentlich et al. 1988; Frankowski et al. 2001). Similarly, laminarinase produced by Pseudomonas stutzeri digest and lyse mycelia of F. solani (Lim et al. 1991). The cell walls of F. oxysporum, R. solani, S. rolfsii, and Pythium ultimum are destroyed by the β-1, 3-glucanase synthesized by Paenibacillus and B. cepacia (Fridlender et al. 1993). The genetic evidence for the role of these enzymes in biocontrol was demonstrated by the genetic modification of E. coli with ChiA. The ChiA transformants showed disease in a number of incidences of southern blight of bean caused by Sclerotium rolfsii (Shapira et al. 1989). Similarly, ChiA from S. marcescens (Haran et al. 1993) transformed into Trichoderma harzianum was strongly able to inhibit Sclerotium rolfsii than the native strain. Trichoderma, a saprophytic fungus, produces a multitude of lysing enzymes and antagonizes pathogens by creating pressure on the available nutrients and space (Olmedo-Monfil and Casas-Flores 2014). A step forward in the paradigm of biocontrol was established by the generation of transgenic plants harboring gene for endochitinase from T. harzianum with increased resistance to plant pathogenic fungi (Lorito et al. 1993). These demonstrations suggest the importance of these enzymes in biocontrol and which could be enhanced using chitinolytic enzymes. In addition, search for other enzymes secreted by the biocontrol agents and their introduction into non-biocontrol microbes or via genetic engineering of plants against a broad range of phytopathogenic fungi could serve as an effective means of control measure.
4.3.4.5 Detoxification of Virulence Factors
The detox system revolves around the interaction of a protein produced by a BCA with another toxin produced by pathogen to decrease its virulence potential of the toxin on a temporary or permanent basis. For instance, Alcaligenes denitrificans and P. dispersa are involved in the detoxification of albicidin toxin produced by Xanthomonas albilineans (Zhang and Birch 1996, 1997; Walker et al. 1988; Basnayake and Birch 1995). Similarly, fusaric acid, a phytotoxin produced by various Fusarium species, is hydrolyzed by strains of B. cepacia and Ralstonia solanacearum (Toyoda and Utsumi 1991; Toyoda et al. 1988).
4.4 Priming and Induced Systemic Resistance
Resistance mediated by plants against various biotic stresses comprising both beneficial and non-beneficial and abiotic factors is distinct. Induced systemic resistance (ISR) in plants resembles systemic acquired resistance (SAR) if bacteria and pathogen remain separated. The complexity of ISR has been explored in a plant model Arabidopsis with three different pathways. Out of three, two involve in the release of pathogenesis-related (PR) proteins with an alternate route induction. In one of the pathways, PR proteins are produced in response to pathogen attack, while in the other pathway, they are produced in response to wounding or necrosis-inducing plant pathogens. In the pathway induced by pathogen, resistance is mediated by salicylic acid (SA) produced by plants, contrary to the wounding pathway that relies on jasmonic acid (JA) as the signaling molecule. Salicylic acid-mediated defense is triggered by pathogen infection that leads to the production of PR proteins such as PR-1, PR-2, chitinases, and some peroxidases (Kageyama and Nelson 2003; Park and Kloepper 2000; Ramamoorthy et al. 2001). These PR proteins can effectively destroy the invading cells and/or augment the cell membranes to withstand infections. On the contrary, the third pathway is rhizobacteria-induced systemic resistance (ISR), leads of systemic resistance, which is elicited by naturally present nonpathogenic bacteria associated with root. The induction of elicitors like volatile compound, protein, and antibiotic by biocontrol agents enhances the gene expression of jasmonic acid/salicylic acid/ethylene pathways (Hase et al. 2008). Trichoderma-emitted terpenes and compound such as 6-pentyl-2H-pyran-2-one-stimulated strains tended plant growth (Lee et al. 2016). BCA like Pythium oligandrum suppresses Ralstonia solanacearum-caused wilt disease in tomato by inducing an ethylene-dependent defense response (Hase et al. 2008). A number of compounds like polyacrylic acid, ethylene, and acetyl salicylic acid, various amino acid derivatives, the herbicide phosphinothricin, and harpin produced by Erwinia amylovora induce resistance of host plant against soilborne pathogens (Wei and Beer 1996). Application of biocontrol fungi, bacteria, bacteriophages, and compounds that induce ISR in the plant has been reported as an effective alternative tool for soilborne disease control.
4.5 Emerging Biocontrol Strategies
4.5.1 Usage of Plant Exudates to Attract Beneficial Biocontrol Microbes
The composition and function of rhizosphere microbial populations are significantly impacted by the exudate secreted by the root. Certain beneficial microbes are attracted by specific root exudates to meet the specific needs. The role of plant chemical exudates in favoring specific microbiomes has been well explored in the past (Rahman et al. 2017). For instance, specific nitrogen-fixing rhizobacteria are attracted by flavonoids released from legumes (Cooper 2007), and some beneficial rhizobacteria aid in activating plant defense responses to combat foliar diseases (Ryu et al. 2004). The application of soil microbiomes in agriculture has been extensively practiced as a strategy to enhance plant nutrition and disease resistance (Cao et al. 2011; Kavoo-Mwangi et al. 2013). The correlation between different exudate profiles and an attraction of different microbial populations was established in hormone-treated plants and defense signaling mutants (Carvalhais et al. 2013, 2015). Furthermore, signaling by strigolactone, a plant hormone, attracted mycorrhiza and other microbes that aid in phosphate solubilization, water supply, and defense (Rahman et al. 2017). The organic compounds malate, succinate, and fumarate aid in the attraction of a beneficial microbe Pseudomonas fluorescens and protect the plant from various pathogen attacks (Oku et al. 2014). Based on the successful demonstrated evidences, the implementation of plant exudates could be one of the viable approaches to attract beneficial microbes to control different plant diseases. In addition, the rhizosphere microbial population could be manipulated by simply spraying plants with signaling chemicals or altering the genotype via plant breeding to attract beneficial microbes (Carvalhais et al. 2015; Wintermans et al. 2016).
4.5.2 Use of Substrates to Maintain Beneficial Biocontrol Microbes
Substrates are the nutrients required for the growth and metabolism of microbes. Beneficial biocontrol microbes can be cultured using specific substrates. The majority of plant-associated microbes can be grown using systematic bacterial isolation approaches (Bai et al. 2015). This is advantageous to harness the beneficial microbiomes from the natural soil microbiota for the biocontrol of plant diseases by providing the right substrates. The nutritional flexibility of beneficial microbes, especially bacteria, renders them suitable for different types of environments.
4.5.3 Phyllosphere Biocontrol
Foliar diseases by fungal pathogens can significantly affect various crop plants (Madden and Nutter 1995; Dean et al. 2012). A better grasp of the role of foliar microbiomes could be a crucial step toward crop protection. Microbial biocontrol agents serve as an eco-friendly alternative to synthetic chemical control (Maksimov et al. 2011). Spray application of microbial biocontrol agents has been found to be effective on foliar diseases, including blights, leaf spots, and mildew (Heydari and Pessarakli 2010). The potential of microbial formulation in controlling stem rot pathogen of avocado plants has been tested (Demoz and Korsten 2006). Several bacteria could inhibit the growth of tomato plant bacterial stem rot pathogen Erwinia chrysanthemi under greenhouse condition (Aysan et al. 2003). Reduced fungal growth was noted on flowers of blueberries treated with the bacterial strain (B. subtilis QRD137) producing the biological products Serenade (Scherm et al. 2004). Plants defend themselves by producing antimicrobial compounds on the leaf surface or by enhancing the proliferation of beneficial microbes through the release of diverse phytochemicals (Vorholt 2012). It has been demonstrated in the past that leaf-colonizing microbes can prevent foliar disease progression in plants (Morris and Monier 2003). Niche occupation is believed to play an important role in the development of crop protection against pathogens (Lindow 1987). The implementation of innovative strategies such as profiling of phyllosphere microbiome (Vorholt 2012) and their interactions with the plant and microbe–microbe interactions can reveal new insights toward plant pathogen mitigation.
4.5.4 Breeding Microbe-Optimized Plants
Plants have evolved to interact with certain type of microbes. For instance, different ecotypes of Arabidopsis showed about fourfold increment in yield when inoculated with the bacterium Pseudomonas simiae WCS417r (Wintermans et al. 2016). This demonstrates that the outcome of the beneficial interaction is influenced by the genetic profile of the plant (Smith et al. 1999). Breeding of plants optimized to attract and maintain encouraging the colonization of beneficial microbes is the prime objective of this approach. The adoption of genetic engineering can lead to the generation of microbe-optimized plants capable of producing exudates attractive to the beneficial bacteria (Trivedi et al. 2017).
4.5.5 Engineering Microbiome, Plant-Optimized Microbes/Microbiomes
This strategy involves engineering or breeding individual microbes or microbial consortia harboring beneficial microbes followed by their maintenance for application on crop plants meant for different soil types. This leads to the formulation of plant-/soil-optimized microbes and plant-/soil-optimized microbiomes that can serve as an inoculum for different crops in different soils. This strategy is rather new, but soil microbiomes have shown evidence of promoting plant–microbe interactions (Berendsen et al. 2012). Naturally occurring plant microbiomes play a protective role in the face of disease development (Bulgarelli et al. 2013).
4.5.6 Pairing Plant Seed with Optimal Microbiome and Soil Amendment Practices for Specific Soil Type
Efforts have been made and are still underway by the researchers to find the microbes that suit a particular crop to grow better. Smearing of seeds with promising microbes for specific soil type is one of the ideal strategies for optimizing plant–microbe interactions. The microbiomes coating the seeds assist the plants to absorb nutrients and as BCA offering protection against pathogens. In order to ensure that beneficial microbes are maintained, certain soil amendments may be essential.
Formulations of beneficial bacteria such as Rhizobium for legume seed treatment have already been in market. Apart from promoting the development of nitrogen-fixing nodules on leguminous plant roots, they also aid in the suppression of pathogens. The effectiveness of granular and aqueous extracts of vermicompost-based bioformulations enriched in microbial growth-promoting compounds has been demonstrated in the past (Kalra et al. 2010). Likewise, Rice et al. (1995) successfully cultured the phosphate-solubilizing fungus Penicillium bilaii with Rhizobium. Enhanced soybean nodulation was noted when co-inoculation of Bradyrhizobium and Bacillus megaterium was conducted (Liu and Sinclair 1990). Recently it was demonstrated that mixtures of rhizobacteria enhanced biological control of multiple plant diseases, promoting plant growth (Liu et al. 2018).
4.6 Current Scenario and the Need of Adopting of BCA in India
Food security is a topmost priority of all countries (Porter et al. 2014), and it is urgent for developing countries with rapid population growth. To meet the nutritional requirement of the ever-growing number of consumers, the production of food crops must be raised. But the excessive reliance on chemical fertilizers and pesticides is an unsustainable paracrine that comes with heavy price in terms of environment as well as organism health.
Despite the rising awareness of the environmental threats, in the developing countries like India, classical biocontrol programs are generally not used for agricultural practices. Therefore, it is important to extensively explore and evaluate their biocontrol potential against pathogens. Pilot program on the mass production of some BCA like Trichoderma can help in managing crop pathologies (Korolev et al. 2008; Cumagun 2014). Trichoderma can modulate the host plant signaling to combat cucumber mosaic virus (Vitti et al. 2015), Fusarium (Wang et al. 2005), and Botrytis cinerea (Elad et al. 1998), among other pathogens.
In Karnataka, the tomato plant wilt caused by Ralstonia solanacearum was abrogated by Pseudomonas fluorescens under greenhouse conditions (Vanitha et al. 2009). So, BCAs hold promises in promoting Indian agriculture, while reducing the dependency on the vicious chemical pesticides.
In order to assist the farmers in adopting new technologies, the government should take several approaches. The use of local languages to generalize literature and enhance financing to the biocontrol projects; if needed, the importing of BCA, promotion of research and development on biocontrol, and formulating manuals of BCA–plant host can be promising initiatives in this regard.
4.7 Future Prospects
In the present scenario of crop production, biocontrol is of utmost importance; however, its application needs to be optimized. Novel BCA can be screened from root microbiome (Lareen et al. 2016). Addition of resistance inducers like Bion (benzo(1,2,3) thiadiazole-7-carbothioic acid S-methyl ester) (BTH) and salicylic acid (SA) improved the efficiency of BCA such as Trichoderma hamatum, Trichoderma harzianum, and Paecilomyces lilacinus (Abo-Elyousr et al. 2009). BCA with synergistic function against phytopathogens might result in desirable outcome.
The research in this area is still confined to the laboratory, and very little attention has been given to formulate profitable bioagents. Moreover, the few cost-effective products have not been used conveniently by the farmers owing to the limited available information regarding their usage. Therefore, initiatives toward the popularization of biological control are required. BCAs which appear promising in laboratory settings often fail when implicated in the field. A myriad of physiological and ecological factors has been recognized causal for the futility. To improve the selection and characterization of BCA, biotechnology and other molecular tools are gaining importance to potentially solve the problem in the near future. For augmenting the efficacy of BCA, different methods such as mutation or protoplasm fusion could be a good intervention. A better understanding of the BCA mechanism and the evaluation of environmental factors is critical for viable marketability. Also, every technology leaves behind a trail of menace, so it is important to account for them, before things go out of control. For example, if BCA turn against the host plant, certain situations must be monitored. This concern is not without foundation, as Pythium touted as a BCA is a phytopathogen as well (Mavrodi et al. 2012; Alsohim et al. 2014). So, efficacy of the BCA mostly hinges on the plant host status, pathogens, and environmental conditions. The temperature, soil water level, moisture, oxygen, carbon, nitrogen, trace elements, indigenous microflora compositions, and the density of BCA have been found to be critical players in the pathogen control performance (Raaijmakers et al. 2002; Innocenti et al. 2015). The nematicidal effect of Pseudomonas fluorescens can be affected by the cyanobacterium Calothrix parietina (Hashem and Abo-Elyousr 2011). Alteration of relations from symbiosis to mutualism to parasitism, with changing milieu, has been reported (Redman et al. 2001). Introduction of alien species often poses environmental risks, so the impact must be assessed. Antibiotics as the driver of “drug resistance” are a grave problem. Similarly, BCA are capable of spreading perils, so they ought to be used in a controlled manner.
4.8 Conclusion
The importance of biocontrol agents in phytopathogen suppression has been known since decades back. However, the laboratory findings have not been successfully implicated in the field. In-depth understanding of the various strategies leading to positive plant-beneficial microbe association is imperative. The combination of microbial biofertilizers, biocontrol microbes, and soil amendments and the planting of microbe-optimized crops can forge positive plant–microbe interactions. In addition, potent bio-formulations and effective application methods need to be developed for successful implementation against a broad range of pathogens on a commercial scale in a cost-effective manner. This is an under-investigated area that deserves major research efforts, as it is paramount for enhancing crop yields and ensuring food security in a sustainable manner.
References
Abo-Elyousr KAM, Hashem M, Ali EH (2009) Integrated control of cotton root rot disease by mixing fungal biocontrol agents and resistance inducers. Crop Prot 28:295–301. https://doi.org/10.1016/j.cropro.2008.11.004
Aboutorabi M (2018) A review on the biological control of plant diseases using various microorganisms. J Res Med Dent Sci 6:30–35
Aktar MW, Sengupta D, Chowdhury A (2009) Impact of pesticides use in agriculture: their benefits and hazards. Interdiscip Toxicol 2:1–12
Alexander BJR, Stewart A (2001) Glasshouse screening for biological control agents of Phytophthora cactorum on apple (Malus domestica). N Z J Crop Hortic Sci 29:159–169
Ali S, Hameed S, Imran A, Iqbal M, Lazarovits G (2014) Genetic, physiological and biochemical characterization of Bacillus sp. strain RMB7 exhibiting plant growth promoting and broad spectrum antifungal activities. Microb Cell Factories 13:144
Alsohim AS, Taylor TB, Barrett GA, Gallie J, Zhang XX, Altamirano-Junqueira AE, Johnson LJ, Rainey PB, Jackson RW (2014) The biosurfactant viscosin produced by Pseudomonas fluorescens SBW25 aids spreading motility and plant growth promotion. Environ Microbiol 16:2267–2281. https://doi.org/10.1111/1462-2920.12469
Alström S (2001) Characteristics of bacteria from oilseed rape in relation to their biocontrol activity against Verticillium dahliae. J Phytopathol 149(2):57–64
Alstrom S, Van Vurde JWL (2001) Endophytic bacteria and biocontrol of plant diseases. In: De Boer SH (ed) Plant pathogenic bacteria. Kluwer Academic Publishers, pp 60–67. https://doi.org/10.1007/978-94-010-0003-1_11
Amin F, Razdan VK, Mohiddin FA, Bhat KA, Sheikh PA (2010) Effect of volatile metabolites of Trichoderma species against seven fungal plant pathogens in-vitro. J Phytol 2:34–37
Arrebola E, Sivakumar D, Korsten L (2010) Effect of volatile compounds produced by Bacillus strains on postharvest decay in citrus. Biol Control 53:122–128. https://doi.org/10.1016/j.biocontrol.2009.11.010
Aysan Y, Karatas A, Cinar O (2003) Biological control of bacterial stem rot caused by Erwinia chrysanthemi on tomato. Crop Prot 22:807–811
Bai Y, Müller DB, Srinivas G, Garrido-Oter R, Potthoff E, Rott M, Dombrowski N, Münch PC, Spaepen S, Remus-Emsermann M (2015) Functional overlap of the Arabidopsis leaf and root microbiota. Nature 528:364
Bais HP, Fall R, Vivanco JM (2004) Biocontrol of Bacillus subtilis against infection of Arabidopsis roots by Pseudomonas syringae is facilitated by biofilm formation and surfactin production. Plant Physiol 134:307–319
Basnayake WVS, Birch RG (1995) A gene from Alcaligenes denitrificans that confers albicidin resistance by reversible antibiotic binding. Microbiology 141:551–560
Berendsen RL, Pieterse CMJ, Bakker PAHM (2012) The rhizosphere microbiome and plant health. Trends Plant Sci 17:478–486
Bloemberg GV, Lugtenberg BJ (2001) Molecular basis of plant growth promotion and biocontrol by rhizobacteria. Curr Opin Plant Biol 4:343–350
Bloemberg GV, Lugtenberg BJJ (2003) Phenazines and their role in biocontrol of Pseudomonas spp. New Phytol 157(3):503–523
Broeckling CD, Broz AK, Bergelson J, Manter DK, Vivanco JM (2008) Root exudates regulate soil fungal community composition and diversity. Appl Environ Microbiol 74:738–744
Bulgarelli D, Schlaeppi K, Spaepen S, van Themaat EVL, Schulze-Lefert P (2013) Structure and functions of the bacterial microbiota of plants. Annu Rev Plant Biol 64:807–838
Campos VP, Pinho RSC, Freire ES (2010) Volatiles produced by interacting microorganisms potentially useful for the control of plant pathogens. Ciênc Agrotec 34:525–535. https://doi.org/10.1590/S1413-70542010000300001
Cao Y, Zhang Z, Ling N, Yuan Y, Zheng X, Shen B, Shen Q (2011) Bacillus subtilis SQR 9 can control Fusarium wilt in cucumber by colonizing plant roots. Biol Fertil Soils 47:495–506
Carvalhais LC, Dennis PG, Fedoseyenko D, Hajirezaei MR, Borriss R, Wirén NV (2011) Root exudation of sugars, amino acids, and organic acids by maize as affected by nitrogen, phosphorus, potassium, and iron deficiency. J Plant Nutr Soil Sci 174:3–11
Carvalhais LC, Dennis PG, Badri DV, Tyson GW, Vivanco JM, Schenk PM (2013) Activation of the jasmonic acid plant defence pathway alters the composition of rhizosphere bacterial communities. PLoS One 8:e56457
Carvalhais LC, Dennis PG, Badri DV, Kidd BN, Vivanco JM, Schenk PM (2015) Linking jasmonic acid signaling, root exudates, and rhizosphere microbiomes. Mol Plant-Microbe Interact 28:1049–1058
Chen S, Shi L, Shan Z, Hu Q (2007) Determination of organochlorine pesticide residues in rice and human and fish fat by simplified two-dimensional gas chromatography. Food Chem 104:1315–1319
Chernin L, Chet I (2002) Enzymes in the environment: activity, ecology, and applications. Marcel Dekker, New York, pp 171–225
Chin-A-Woeng TF, Bloemberg GV, van der Bij AJ, van der Drift KM, Schripsema J, Kroon B, Scheffer RJ, Keel C, Bakker PA, Tichy HV, de Bruijn FJ (1998) Biocontrol by phenazine-1-carboxamide-producing Pseudomonas chlororaphis PCL1391 of tomato root rot caused by Fusarium oxysporum f. sp. radicis-lycopersici. Mol Plant-Microbe Interact 11:1069–1077. https://doi.org/10.1094/MPMI.1998.11.11.1069
Chitra GA, Muraleedharan VR, Swaminathan T, Veeraraghavan D (2006) Use of pesticides and its impact on health of farmers in South India. Int J Occup Environ Health 12:228–233
Compant S, Duffy B, Nowak J, Clément C, Barka EA (2005) Use of plant growth-promoting bacteria for biocontrol of plant diseases: principles, mechanisms of action, and future prospects. Appl Environ Microbiol 71:4951–4959. https://doi.org/10.1128/AEM.71.9.4951-4959.2005
Compant S, Duffy B, Nowak J, Clement C, Barka EA (2013) Use of plant growth promoting bacteria for biocontrol of plant diseases: principles, mechanisms of action, and future prospects. Appl Environ Microbiol 71:4951–4959
Cooper J (2007) Early interactions between legumes and rhizobia: disclosing complexity in a molecular dialogue. J Appl Microbiol 103:1355–1365
Costa JM, Loper JE (1994) Characterization of siderophore production by the biological-control agent Enterobacter cloacae. Mol Plant-Microbe Interact 7:440–448
Cumagun CJR (2014) Advances in formulation of Trichoderma for biocontrol. In: Gupta VK, Schmoll M, Herrera-Estrella A, Upadhyay RS, Druzhinina I, Tuohy M (eds) Biotechnology and biology of Trichoderma. Elsevier, Amsterdam, pp 527–531
D’aes J, Hua GK, De Maeyer K, Pannecoucque J, Forrez I, Ongena M, Dietrich LE, Thomashow LS, Mavrodi DV, Höfte M (2011) Biological control of Rhizoctonia root rot on bean by phenazine- and cyclic lipopeptide-producing Pseudomonas CMR12a. Phytopathology 101:996–1004
Danovaro R, Bongiorni L, Corinaldesi C, Giovannelli D, Damiani E, Astolfi P, Greci L, Pusceddu A (2008) Sunscreens cause coral bleaching by promoting viral infections. Environ Health Perspect 116:441–447
de Weert S, Vermeiren H, Mulders IH, Kuiper I, Hendrickx N, Bloemberg GV, Vanderleyden J, De Mot R, Lugtenberg BJ (2002) Flagella-driven chemotaxis towards exudate components is an important trait for tomato root colonization by Pseudomonas fluorescens. Mol Plant-Microbe Interact 15:1173–1180
Dean R, Van Kan JA, Pretorius ZA, Hammond-Kosack KE, Di Pietro A, Spanu PD, Rudd JJ, Dickman M, Kahmann R, Ellis J (2012) The top 10 fungal pathogens in molecular plant pathology. Mol Plant Pathol 13:414–430
Degenhardt J, Gershenzon J, Baldwin IT et al (2003) Attracting friends to feast on foes: engineering terpene emission to make crop plants more attractive to herbivore enemies. Curr Opin Biotechnol 14:169–176
Demoz BT, Korsten L (2006) Bacillus subtillis attachment, colonization, and survival on avocado flowers and its mode of action on stem-end rot pathogens. Biol Control 37:68–74
Dubey RK, Tripathi V, Abhilash PC (2015) Book review: principles of plant-microbe interactions: microbes for sustainable agriculture. Front Plant Sci 6:986
Duffy BK (2001) Encyclopedia of plant pathology. Wiley, New York, pp 243–244
Dunlap CA, Bowman MJ, Schisler DA (2013) Genomic analysis and secondary metabolite production in Bacillus amyloliquefaciens AS 43.3: a biocontrol antagonist of Fusarium head blight. Biol Control 64(2):166–175
Elad Y, Kirshner B, Yehuda N, Sztejnberg A (1998) Management of powdery mildew and gray mold of cucumber by Trichoderma harzianum T39 and Ampelomyces quisqualis AQ10. BioControl 43:241–251. https://doi.org/10.1023/A:1009919417481
Escudero N, Ferreira SR, Lopez-Moya F (2016) Chitosan enhances parasitism of Meloidogyne javanica eggs by the nematophagous fungus Pochonia chlamydosporia. Fungal Biol 120:572–585. https://doi.org/10.1016/j.funbio.2015.12.005
Fernando DWG, Ramarathnama R, Krishnamoorthy AS, Savchuk SC (2005) Identification and use of potential bacterial organic antifungal volatiles in biocontrol. Soil Biol Biochem 37:955–964. https://doi.org/10.1016/j.soilbio.2004.10.021
Frankowski J, Lorito M, Scala F et al (2001) Purification and properties of two chitinolytic enzymes of Serratia plymuthica HRO-C48. Arch Microbiol 176:421–426
Fridlender M, Inbar J, Chet I (1993) Biological control of soilborne plant pathogens by a β-1,3 glucanase-producing Pseudomonas cepacia. Soil Biol Biochem 25:1211–1221
Giorgio A, Lo Cantore P, Shanmugaiah V, Lamorte D, Iacobellis NS (2015) Rhizobacteria isolated from common bean in southern Italy as potential biocontrol agents against common bacterial blight. Eur J Plant Pathol 144(2):297–309. https://doi.org/10.1007/s10658-015-0767-8
Goswami J, Pandey RK, Tewari JP, Goswami BK (2008) Management of root knot nematode on tomato through application of fungal antagonists, Acremonium strictum and Trichoderma harzianum. Arch Phytopathol Plant Protect 43(3):237–240
Govindappa M, Lokesh S, Ravishankar RV, Rudra Naik V, Raju SG (2010) Induction of systemic resistance and management of safflower Macrophomina phaseolina root-rot disease by biocontrol agents. Arch Phytopathol Plant Protect 43(1):26–24
Gu YQ, Mo MH, Zhou JP, Zou CS, Zhang KQ (2007) Evaluation and identification of potential organic nematicidal volatiles from soil bacteria. Soil Biol Biochem 39:2567–2575. https://doi.org/10.1016/j.soilbio.2007.05.011
Guigon-Lopez C, Vargas-Albores F, Guerrero-Prieto V (2015) Changes in Trichoderma asperellum enzyme expression during parasitism of the cotton root rot pathogen Phymatotrichopsis omnivora. Fungal Biol 119:264–273. https://doi.org/10.1016/j.funbio.2014.12.013
Guo Q, Dong W, Li S, Lu X, Wang P, Zhang X, Wang Y, Ma P (2014) Fengycin produced by Bacillus subtilis NCD-2 plays a major role in biocontrol of cotton seedling damping-off disease. Microbiol Res 169:533–540
Handelsman J, Parke JL (1989) Plant-microbe interactions. In: Molecular and genetic perspectives, vol 3. McGraw-Hill, New York, pp 27–61
Haran S, Schickler H, Peer S, Logemann S, Oppenheim A, Chet I (1993) Increased constitutive chitinase activity in transformed Trichoderma harzianum. Biol Control 3:101–108
Harman GE, Nelson EB (1994) Seed treatment: progress and prospects. BCPC, Farnham, pp 283–292
Hase S, Takahashi S, Takenaka S (2008) Involvement of jasmonic acid signalling in bacterial wilt disease resistance induced by biocontrol agent Pythium oligandrum in tomato. Plant Pathol 57:870–876. https://doi.org/10.1111/j.1365-3059.2008.01858.x
Hashem M, Abo-Elyousr KA (2011) Management of the root-knot nematode Meloidogyne incognita on tomato with combinations of different biocontrol organisms. Crop Prot 30:285–292. https://doi.org/10.1016/j.cropro.2010.12.009
Heisler J, Glibert P, Burkholder J, Anderson D, Cochlan W, Dennison W, Gobler C, Dortch Q, Heil C, Humphries E, Lewitus A, Magnien R, Marshall H, Sellner K, Stockwell D, Stoecker D, Suddleson M (2008) Eutrophication and harmful algal blooms: a scientific consensus. Harmful Algae 8:3–13
Heydari A, Pessarakli M (2010) A review on biological control of fungal plant pathogens using microbial antagonists. J Biol Sci 10:273–290
Hider RC, Kong X (2010) Chemistry and biology of siderophores. Nat Prod Rep 27:637–657
Huang J, Wei Z, Hu J (2017) Chryseobacterium nankingense sp. nov. WR21 effectively suppresses Ralstonia solanacearum growth via intensive root exudates competition. BioControl 62:567–577. https://doi.org/10.1007/s10526-017-9812-1
Hussain T, Khan AA (2020) Bacillus subtilis HussainT-AMU and its antifungal activity against potato black scurf caused by Rhizoctonia solani. Biocatal Agric Biotechnol 23:101433
Innocenti G, Roberti R, Piattoni F (2015) Biocontrol ability of Trichoderma harzianumstrain T22 against Fusarium wilt disease on water-stressed lettuce plants. BioControl 60:573–581. https://doi.org/10.1007/s10526-015-9662-7
Jagannath A, Shore RF, Walker LA, Ferns PN, Gosler AG (2008) Eggshell pigmentation indicates pesticide contamination. J Appl Ecol 45:133–140
Jamalizadeh M, Etebarian HR, Aminian H, Alizadeh A (2011) A review of mechanisms of action of biological control organisms against post-harvest fruit spoilage. EPPO Bull 41:65–71
John RP, Tyagi RD, Prévost D, Brar S, Pouleur S, Surampalli R (2010) Mycoparasitic Trichoderma viride as a biocontrol agent against Fusarium oxysporum f. sp. adzuki and Pythium arrhenomanes and as a growth promoter of soybean. Crop Prot 29:1452–1459. https://doi.org/10.1016/j.cropro.2010.08.004
Kageyama K, Nelson EB (2003) Differential inactivation of seed exudate stimulation of Pythium ultimum sporangium germination by Enterobacter cloacae influences biological control efficacy on different plant species. Appl Environ Microbiol 69(2003):1114–1120
Kai M, Haustein M, Molina F, Petri A, Scholz B, Piechulla B (2009) Bacterial volatiles and their action potential. Appl Microbiol Biotechnol 81:1001–1012. https://doi.org/10.1007/s00253-008-1760-3
Kalra A, Chandra M, Awasthi A, Singh AK, Khanuja SPS (2010) Natural compounds enhancing growth and survival of rhizobial inoculants in vermicompost based formulations. Biol Fertil Soils 46:521–524
Karima, Haggag HE, Nadia G EG (2012) In vitro study on Fusarium solani and Rhizoctonia solani isolates causing the damping off and root rot diseases in tomatoes. Nat Sci 10:16–25
Karthikeyan V, Sankaralingam A, Akkeeran S (2007) Biological control of groundnut stem rot caused by Sclerotium rolfsii (Sacc.). Arch Phytopathol Plant Protect 39(3):215–223
Kasiotis KM, Anagnostopoulos C, Anastasiadou P, Machera K (2014) Pesticide residues in honeybees, honey and bee pollen by LC-MS/MS screening: reported death incidents in honeybees. Sci Total Environ 485–486:633–642
Kavitha S, Senthilkumar S, Gnanamanickam S (2005) Isolation and partial characterization of antifungal protein from Bacillus polymyxa strain VLB16. Process Biochem 40(10):3236–3243
Kavoo-Mwangi A, Kahangi E, Ateka E, Onguso J, Mukhongo R, Mwangi E, Jefwa J (2013) Growth effects of microorganisms based commercial products inoculated to tissue cultured banana cultivated in three different soils in Kenya. Appl Soil Ecol 64:152–162
Kawahara J, Horikoshi R, Yamaguchi T, Kumagai K, Yanagisawa Y (2005) Air pollution and young children’s inhalation exposure to organophosphorus pesticide in an agricultural community in Japan. Environ Int 31:1123–1132
Keel C, Schnider U, Maurhofer M (1992) Suppression of root diseases by Pseudomonas fluorescens CHAO: importance of the bacterial secondary metabolite 2,4-diacetylphloroglucinol. Mol Plant-Microbe Interact 5(1992):4–13
Kerr A (1980) Biological control of crown gall through production of agrocin 84. Plant Dis 64:25–30
Kloeppe JW, Rodríguez-Kábana R, Zehnder AW, Murphy JF, Sikora E, Fernández C (1999) Plant root-bacterial interactions in biological control of soilborne diseases and potential extension to systemic and foliar diseases. Australas Plant Pathol 28:21–26
Kloepper JW, Leong J, Teinize M, Schroth MN (1980) Enhanced plant growth by siderophores produced by plant growth promoting rhizobacteria. Nature 286:885–886
Kloepper JW, Ryu CM, Zhang S (2004) Induced systemic resistance and promotion of plant growth by Bacillus spp. Phytopathology 94:1259–1266
Kokalis A, Burelle N, Vavrina CS, Rosskopf EM, Shelby RA (2002) Field evaluation of plant growth-promoting rhizobacteria amended transplant mixes and soil solarization for tomato and pepper production in Florida. Plant Soil 238:257–266
Korolev N, Rav David D, Elad Y (2008) The role of phytohormones in basal resistance and Trichoderma-induced systemic resistance to Botrytis cinerea in Arabidopsis thaliana. BioControl 53:667–683. https://doi.org/10.1007/s10526-007-9103-3
Kubicek CP, Mach RL, Peterbauer CK, Lorito M (2001) Trichoderma: from genes to biocontrol. J Plant Pathol 83:11–23
Lam ST, Gaffney TD (1993) Biotechnology in plant disease control. Wiley, New York, pp 291–320
Lareen A, Burton F, Schäfer P (2016) Plant root-microbe communication in shaping root microbiomes. Plant Mol Biol 90:575–587
Lee S, Yap M, Behringer G, Hung R, Bennett JW (2016) Volatile organic compounds emitted by Trichoderma species mediate plant growth. Fungal Biol Biotechnol 3:7. https://doi.org/10.1186/s40694-016-0025-7
Leong SA, Expert D (1989) Plant-microbe interactions. In: Molecular and genetic perspectives, vol 3. McGraw-Hill, New York, pp 62–83
Lim HS, Kim YS, Kim SD (1991) Pseudomonas stutzeri YPL-1 genetic transformation and antifungal mechanism against Fusarium solani, an agent of plant root rot. Appl Environ Microbiol 57:510–516
Lindow SE (1987) Competitive exclusion of epiphytic bacteria by Ice-Pseudomonas syringae mutants. Appl Environ Microbiol 53:2520–2527
Liu Z, Sinclair J (1990) Enhanced soybean plant growth and nodulation by Bradyrhizobium in the presence of strains of Bacillus megaterium. Phytopathology 80:1024
Liu W, Wu W, Zhu B, Du Y, Liu F (2008) Antagonistic activities of volatiles from four strains of Bacillus spp. and Paenibacillus spp. against soil-borne plant pathogens. Agric Sci China 7:1104–1114. https://doi.org/10.1016/S1671-2927(08)60153-4
Liu K, McInroy JA, Hu CH, Kloepper JW (2018) Mixtures of plant-growth-promoting rhizobacteria enhance biological control of multiple plant diseases and plant-growth promotion in the presence of pathogens. Plant Dis 102:67–72
Loper JE, Buyer JS (1991) Siderophores in microbial interactions on plant surfaces. Mol Plant-Microbe Interact 4:5–13
Loper JE, Henkels MD (1997) Availability of iron to Pseudomonas fluorescens in rhizosphere and bulk soil evaluated with an ice nucleation reporter gene. Appl Environ Microbiol 63:99–105
Lorito M, Harman GE, Hayes CK, Broadway RM, Tronsmo A, Woo SL, Di Pietro A (1993) Chitinolytic enzymes produced by Trichoderma harzianum: antifungal activity of purified endochitinase and chitobiosidase. Phytopathol 83(3):302–307
Mackie AE, Wheatley RE (1999) Effects and incidence of volatile organic compound interactions between soil bacterial and fungal isolates. Soil Biol Biochem 31:375–385. https://doi.org/10.1016/S0038-0717(98)00140-0
Madden L, Nutter F Jr (1995) Modeling crop losses at the field scale. Can J Plant Pathol 17:124–137
Maheshwari DK (2012) Bacteria in agrobiology: disease management. Springer, Berlin
Maksimov I, Abizgil’Dina R, Pusenkova L (2011) Plant growth promoting rhizobacteria as alternative to chemical crop protectors from pathogens. Appl Biochem Microbiol 47:333–345
Mannaa M, Kim KD (2018) Biocontrol activity of volatile-producing Bacillus megateriumandPseudomonas protegens against AspergillusandPenicillium spp. predominant in stored rice grains: study II. Mycobiology 46:52–63. https://doi.org/10.1080/12298093.2018.1454015
Matny ON (2015) Fusarium head blight and crown rot on wheat & barley: losses and health risks. Adv Plants Agric Res 2:38–43
Mavrodi OV, Walter N, Elateek S, Taylor CG, Okubara PA (2012) Suppression of Rhizoctonia and Pythium root rot of wheat by new strains of Pseudomonas. Biol Control 62:93–102. https://doi.org/10.1016/j.biocontrol.2012.03.013
Mbarga JB, Ten Hoopen GM, Kuaté J, Adiobo A, Ngonkeu MEL, Ambang Z, Akoa A, Tondje PR, Begoude BAD (2012) Trichoderma asperellum: a potential biocontrol agent for Pythium myriotylum, causal agent of cocoyam (Xanthosomas agittifolium) root rot disease in Cameroon. Crop Prot 36:18–22
Meena M, Swapnil P, Zehra A, Dubey MK, Upadhyay RS (2017) Antagonistic assessment of Trichoderma spp. by producing volatile and non-volatile compounds against different fungal pathogens. Arch Phytopathol Plant Protect 50:629–648. https://doi.org/10.1080/03235408.2017.1357360
Mnif W, Hassine AI, Bouaziz A, Bartegi A, Thomas O, Roig B (2011) Effect of endocrine disruptor pesticides: a review. Int J Environ Res Public Health 8:2265–2303
Morris CE, Monier JM (2003) The ecological significance of biofilm formation by plant-associated bacteria. Annu Rev Phytopathol 41:429–453
Mostert D, Molina AB, Daniells J, Fourie G, Hermanto C, Chao C-P, Fabregar E, Sinohin VG, Masdek N, Thangavelu R, Li C, Yi G, Mostert L, Viljoen A (2017) The distribution and host range of the banana Fusarium wilt fungus, Fusarium oxysporumf. sp. cubense, in Asia. PLoS One 12:e0181630
Neilands JB (1981) Iron absorption and transport in microorganisms. Annu Rev Nutr 1:27–46
Nelson EB (1990) Exudate molecules initiating fungal responses to seeds and roots. Plant Soil 129:61–73
Neupane D, Jors E, Brandt L (2014) Pesticide use, erythrocyte acetylcholinesterase level and self-reported acute intoxication symptoms among vegetable farmers in Nepal: a cross-sectional study. Environ Health 13:98
Nihorimbere V, Cawoy H, Seyer A, Brunelle A, Thonart P, Ongena M (2011) Impact of rhizosphere factors on cyclic lipopeptide signature from the plant beneficial strain Bacillus amyloliquefaciens S499. FEMS Microbiol Ecol 79:176–191
O’Brien M (2000) Have lessons been learned from the UK bovine spongiform encephalopathy (BSE) epidemic? Int J Epidemiol 29:730–733
O’Callaghan M, Lorenz N, Gerard EM (2006) Characterization of phylloplane and rhizosphere microbial populations using PCR and denaturing gradient gel electrophoresis (DGGE). In: Cooper JE, Rao JR (eds) Molecular approaches to soil rhizosphere and plant microorganism analysis. CABI, Oxfordshire, pp 99–115
Oclarit E, Cumagun CJR (2010) Evaluation of efficacy of Paecilomyces lilacinus as biological control agent of Meloidogyne incognita attacking tomato. J Plant Protect 49(4):337–340
Oku S, Komatsu A, Nakashimada Y, Tajima T, Kato J (2014) Identification of Pseudomonas fluorescens chemotaxis sensory proteins for malate, succinate, and fumarate, and their involvement in root colonization. Microbes Environ 29:413–419
Olmedo-Monfil V, Casas-Flores S (2014) Molecular mechanisms of biocontrol in Trichoderma spp. and their applications in agriculture. In: Gupta VK, Schmoll M, Herrera-Estrella A, Upadhyay RS, Druzhinina I, Tuohy MG (eds) Biotechnology and biology of Trichoderma. Elsevier, Waltham, pp 429–453
Ordentlich A, Elad Y, Chet I (1988) The role of chitinase of Serratia marcescens in biocontrol of Sclerotium rolfsii. Phytopathology 78:84–88
Park KS, Kloepper JW (2000) Activation of PR-1a promoter by rhizobacteria that induce systemic resistance in tobacco against Pseudomonas syringae pv. tabaci. Biol Control 18:2–9
Pearson DE, Callaway RM (2003) Indirect effects of host-specific biological control agents. Trends Ecol Evol 18:456–461
Pichersky E, Noel J, Dudareva N (2006) Biosynthesis of plant volatiles: nature’s diversity and ingenuity. Science 311:808–811. https://doi.org/10.1126/science.1118510
Porter JR, Xie L, Challinor AJ et al (2014) Food security and food production systems. In: Climate change 2014: impacts, adaptation, and vulnerability. Part A: global and sectoral aspects. Contribution of Working Group II to the Fifth Assessment Report of the Intergovernmental Panel on Climate Change, pp 485–533
Pozo MJ, Azcón-Aguilar C (2007) Unraveling mycorrhiza-induced resistance. Curr Opin Plant Biol 10:393–398
Prashar P, Shah S (2016) Impact of fertilizers and pesticides on soil microflora in agriculture. In: Lichtfouse E (ed) Sustainable agriculture reviews 19. Springer, Dordrecht. https://doi.org/10.1007/978-3-319-26777-7_8
Prashar P, Kapoor N, Sachdeva S (2014) Rhizosphere: its structure, bacterial diversity and significance. Rev Environ Sci Biotechnol 13:63–77
Raaijmakers JM, Vlami M, de Souza JT (2002) Antibiotic production by bacterial biocontrol agents. Antonie Van Leeuwenhoek 81:537–547. https://doi.org/10.1023/A:1020501420831
Rahman SF, Singh E, Pieterse CMJ, Schenk PM (2017) Emerging microbial biocontrol strategies for plant pathogens. Plant Sci 267:102–111
Ramamoorthy V, Viswanathan R, Raguchander T, Prakasam V, Samiyappan R (2001) Induction of systemic resistance by plant growth promoting rhizobacteria in crop plants against pests and diseases. Crop Prot 20:1–11
Ramarathnam R, Fernando WGD, de Kievit T (2011) The role of antibiosis and induced systemic resistance, mediated by strains of Pseudomonas chlororaphis, Bacillus cereus and B. amyloliquefaciens, in controlling blackleg disease of canola. BioControl 56:225–235. https://doi.org/10.1007/s10526-010-9324-8
Rastogi SK, Tripathi S, Ravishanker D (2010) A study of neurologic symptoms on exposure to organophosphate pesticides in the children of agricultural workers. Indian J Occup Environ Med 14:54–57
Redman RS, Dunigan DD, Rodriguez RJ (2001) Fungal symbiosis from mutualism to parasitism: who controls the outcome, host or invader? New Phytol 151:705–716. https://doi.org/10.1046/j.0028-646x.2001.00210.x
Rice W, Olsen P, Leggett M (1995) Co-culture of Rhizobium meliloti and a phosphorus solubilizing fungus (Penicillium bilaii) in sterile peat. Soil Biol Biochem 27:703–705
Roberts MJ, Schimmelpfennig DE, Ashley E, Livingston MJ, Ash MS, Vasavada U (2006) The value of plant disease early-warning systems: a case study of USDA’s soybean rust coordinated framework. United States Department of Agriculture, Economic Research Service
Rovira AD (1965) Interactions between plant roots and soil microorganisms. Annu Rev Microbiol 19:241–266
Ryu CM, Farag MA, Hu CH, Reddy MS, Kloepper JW, Paré PW (2004) Bacterial volatiles induce systemic resistance in Arabidopsis. Plant Physiol 134:1017–1026
Sahebani N, Hadavi N (2008) Biological control of the root-knot nematode Meloidogyne javanica by Trichoderma harziannum. Soil Biol Biochem 40(8):2016–2020
Scherm H, Ngugi H, Savelle A, Edwards J (2004) Biological control of infection of blueberry flowers caused by Monilinia vaccinii-corymbosi. Biol Control 29:199–206
Schwartz NA, von Glascoe CA, Torres V, Ramos L, Soria-Delgado C (2015) “Where they (live, work and) spray”: pesticide exposure, childhood asthma and environmental justice among Mexican-American farmworkers. Health Place 32:83–92
Shapira R, Ordentlich A, Chet I et al (1989) Control of plant diseases by chitinase expressed from cloned DNA in Escherichia coli. Phytopathology 79:1246–1249
Shoda M (2000) Bacterial control of plant diseases. J Biosci Bioeng 89(6):515–521
Smith KP, Handelsman J, Goodman RM (1999) Genetic basis in plants for interactions with disease-suppressive bacteria. Proc Natl Acad Sci 96:4786–4790
Song M, Yun HY, Kim YH (2014) Antagonistic Bacillus species as a biological control of ginseng root rot caused by Fusarium cf. incarnatum. J Ginseng Res 38(2):136–145
Strobel GA, Dirkse E, Sears J, Markworth C (2001) Volatile antimicrobials from Muscodor albus, a novel endophytic fungus. Microbiology 147:2943–2950. https://doi.org/10.1099/00221287-147-11-2943
Sturz AV, Christie BR (2003) Beneficial microbial allelopathies in the root zone: the management of soil quality and plant disease with rhizobacteria. Soil Tillage Res 72(2):107–123
Sullivan NJ, O’Gara F (1992) Traits of fluorescent Pseudomonas spp. involved in suppression of plant root pathogens. Microbiol Rev 56:662–676
Takahashi H (2013) Auxin biology in roots. Plant Roots 7:49–64
Thomashow LS, Weller DM, Bonsall RF, Pierson LS (1990) Production of the antibiotic phenazine-1-carboxylic acid by fluorescent Pseudomonas species in the rhizosphere of wheat. Appl Environ Microbiol 56:908–912
Toyoda H, Utsumi R (1991) U.S. Patent 4:988,586
Toyoda H, Hashimoto H, Utsumi R (1988) Detoxification of fusaric acid by a fusaric acid-resistant mutant of Pseudomonas solanacearum and its application to biological control of Fusarium wilt of tomato. Phytopathology 78:1307–1311
Trivedi P, Schenk PM, Wallenstein MD, Singh BK (2017) Tiny microbes, big yields: enhancing food crop production with biological solutions. Microb Biotechnol 10:999–1003
van Dijk K, Nelson EB (2000) Fatty acid competition as a mechanism by which Enterobacter cloacae suppresses Pythium ultimum sporangium germination and damping-off. Appl Environ Microbiol 66:5340–5347
Vanitha SC, Niranjana SR, Mortensen CN, Umesha S (2009) Bacterial wilt of tomato in Karnataka and its management by Pseudomonas fluorescens. BioControl 54:685–695. https://doi.org/10.1007/s10526-009-9217-x
Verma M, Brar SK, Tyagi RD (2007) Antagonistic fungi, Trichoderma spp.: panoply of biological control. Biochem Eng J 37:1–20
Vitti A, La Monaca E, Sofo A et al (2015) Beneficial effects of Trichoderma harzianum T-22 in tomato seedlings infected by Cucumber mosaic virus (CMV). BioControl 60:135–147. https://doi.org/10.1007/s10526-014-9626-3
Vorholt JA (2012) Microbial life in the phyllosphere. Nat Rev Microbiol 10:828–840
Walker MJ, Birch RG, Pemberton JM (1988) Cloning and characterization of an albicidin resistance gene from Klebsiella oxytoca. Mol Microbiol 2:443–454
Wan MG, Li GQ, Zhang JB, Jiang DH, Huang HC (2008) Effect of volatile substances of Streptomyces platensis F-1 on control of plant fungal diseases. Biol Control 46:552–559. https://doi.org/10.1016/j.biocontrol.2008.05.015
Wang H, Chang KF, Hwang SF et al (2005) Fusarium root rot of coneflower seedlings and integrated control using Trichoderma and fungicides. BioControl 50:317–329. https://doi.org/10.1007/s10526-004-0457-5
Wei ZM, Beer SV (1996) Harpin from Erwinia amylovora induces plant resistance. Acta Hortic 411:223–225
Welbaum G, Sturz AV, Dong Z (2004) Fertilizing soil microorganisms to improve productivity of agroecosystems. Crit Rev Plant Sci 23:175–193
Weller DM, Landa BB, Mavrodi OV et al (2007) Role of 2,4-diacetylphloroglucinol-producing fluorescent Pseudomonas spp. in the defense of plant roots. Plant Biol 9(2007):4–20
Wheatley RE (2002) The consequences of volatile organic compound mediated bacterial and fungal interactions. A Van Leeuw J Microb 81:357–364. https://doi.org/10.1023/A:1020592802234
Whipps JM (2001) Microbial interactions and biocontrol in the rhizosphere. J Exp Bot 52:487–511
Wintermans PC, Bakker PA, Pieterse CM (2016) Natural genetic variation in Arabidopsis for responsiveness to plant growth-promoting rhizobacteria. Plant Mol Biol 90:623–634
Zakaria H, Kassab AS, Shamseldean M, Oraby M, El-Mourshedy MMF (2013) Controlling the root-knot nematode, Meloidogyne incognita in cucumber plants using some soil bioagents and some amendments under simulated field conditions. Ann Agric Sci 58:77–82. https://doi.org/10.1016/j.aoas.2013.01.011
Zhang L, Birch RG (1996) Biocontrol of sugar cane leaf scald disease by an isolate of Pantoea dispersa which detoxifies albicidin phytotoxins. Lett Appl Microbiol 22:132–136
Zhang L, Birch RG (1997) The gene for albicidin detoxification from Pantoea dispersa encodes an esterase and attenuates pathogenicity of Xanthomonas albilineans to sugarcane. Proc Natl Acad Sci U S A 94:9984–9989
Zhou L, Yuen G, Wang Y (2016) Evaluation of bacterial biological control agents for control of root-knot nematode disease on tomato. Crop Prot 84:8–13. https://doi.org/10.1016/j.cropro.2015.12.009
Zou CS, Mo MH, Gu YQ, Zhou JP, Zhang KQ (2007) Possible contributions of volatile-producing bacteria to soil fungistasis. Soil Biol Biochem 39:2371–2379. https://doi.org/10.1016/j.soilbio.2007.04.009
Conflict of Interest
None of the Authors have conflict of interest.
Author information
Authors and Affiliations
Editor information
Editors and Affiliations
Rights and permissions
Copyright information
© 2020 Springer Nature Singapore Pte Ltd.
About this chapter
Cite this chapter
Hussain, T., Akthar, N., Aminedi, R., Danish, M., Nishat, Y., Patel, S. (2020). Role of the Potent Microbial Based Bioagents and Their Emerging Strategies for the Ecofriendly Management of Agricultural Phytopathogens. In: Singh, J., Yadav, A. (eds) Natural Bioactive Products in Sustainable Agriculture. Springer, Singapore. https://doi.org/10.1007/978-981-15-3024-1_4
Download citation
DOI: https://doi.org/10.1007/978-981-15-3024-1_4
Published:
Publisher Name: Springer, Singapore
Print ISBN: 978-981-15-3023-4
Online ISBN: 978-981-15-3024-1
eBook Packages: Biomedical and Life SciencesBiomedical and Life Sciences (R0)